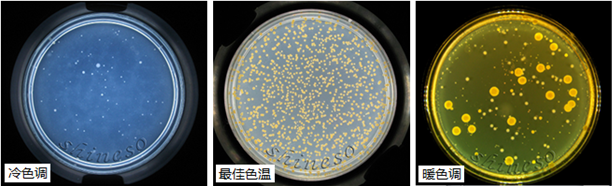
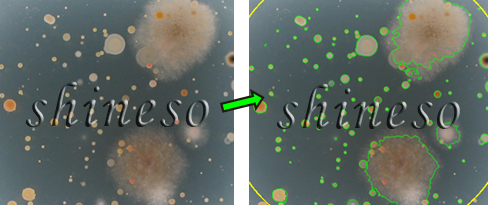

MF3 顯微細(xì)胞分析、菌落計(jì)數(shù)、篩選、抑菌圈測(cè)量聯(lián)用儀

MF系列多功能一體機(jī)是由菌落和抑菌圈成像系統(tǒng)、顯微成像系統(tǒng)及圖像分析軟件構(gòu)成的,有助于實(shí)現(xiàn)微生物常規(guī)實(shí)驗(yàn)的智能化:顯微細(xì)胞觀察和分析、菌落自動(dòng)計(jì)數(shù)和篩選、抑菌圈測(cè)量和效價(jià)分析。高端實(shí)用型的MF3是迅數(shù)科技推出的原MF系列的升級(jí)產(chǎn)品,專為大型檢測(cè)機(jī)構(gòu)而設(shè)計(jì)。配置奧林巴斯CX31顯微鏡,可以輕松捕獲銳利、清晰、平坦的顯微圖像,便于顯微觀察和分析。
顯微圖像分析
顯微圖像采集 “動(dòng)靜態(tài)雙路并行觀察技術(shù)”將顯微光學(xué)圖像轉(zhuǎn)為數(shù)字信號(hào),可在液晶屏上輕松觀察顯微細(xì)胞的運(yùn)動(dòng),隨時(shí)抓取高清靜態(tài)圖片。

顯微測(cè)量功能 可以精確測(cè)量顆粒的直徑、角度、弧度、周長、面積,以及手動(dòng)繪制的任意直線、弧線、曲線的長度等,并自動(dòng)生成測(cè)量結(jié)果。

圖像處理與編輯 內(nèi)置27種圖像處理方法,如自適應(yīng)增強(qiáng)、彩色分量增強(qiáng)、圖像平整、邊緣銳化、濾波、邊緣檢測(cè)、形態(tài)學(xué)運(yùn)算等,可顯著提高顯微觀察效果,滿足高端用戶的特殊需求。文字和圖形嵌入工具,為科研論文的寫作提供幫助。

顆粒自動(dòng)統(tǒng)計(jì) 具備大量統(tǒng)計(jì)功能,可對(duì)顆粒、細(xì)胞進(jìn)行快速計(jì)數(shù),如區(qū)域統(tǒng)計(jì)、直徑分類統(tǒng)計(jì)、顏色識(shí)別統(tǒng)計(jì)、粘連分割、雜質(zhì)剔除、鼠標(biāo)點(diǎn)擊統(tǒng)計(jì)等。

菌落計(jì)數(shù)
全封閉暗箱拍攝 采用全封閉、寬光帶照明技術(shù),符合人體工學(xué)的舷窗門設(shè)計(jì),隔絕環(huán)境光的干擾,徹底消除雜散光在玻璃培養(yǎng)皿折射形成的光斑、光環(huán)現(xiàn)象,為精確活菌計(jì)數(shù)提供了必備的光影條件。上光源呈360度柔性混合光照明,可突顯菌落的色澤和紋理;下光源為晶銳懸浮式暗視野照明,可以清晰勾勒菌落輪廓。

三色LED混合光源、色溫調(diào)節(jié) 科學(xué)研究希望能真實(shí)反應(yīng)菌落的色澤,而白光LED照明成像偏藍(lán)。迅數(shù)采用低功耗、環(huán)保型三色LED混合光,通過暖色光和冷色光的配比,控制色溫范圍為3500K-8500k,拍攝出最真實(shí)的菌落色澤。
輔助光源--雙波長紫外 內(nèi)置254nm紫外燈,可解決菌落儀長期使用帶來的污染問題,也能滿足紫外誘變的需要。雙側(cè)366nm紫外照明設(shè)計(jì)能激發(fā)菌落熒光,滿足大腸埃希氏菌、綠色熒光蛋白等的觀察。
常見菌落計(jì)數(shù) 迅數(shù)為常見平皿的菌落計(jì)數(shù)問題,如細(xì)菌、霉菌、放線菌、霉菌和酵母、大腸菌群、金黃色葡萄球菌、網(wǎng)格濾膜、3M測(cè)試片、螺旋平皿等,提供了方便快捷的一鍵智能統(tǒng)計(jì)和高級(jí)統(tǒng)計(jì)工具。

復(fù)雜菌落計(jì)數(shù)-多菌混雜 某些培養(yǎng)皿會(huì)出現(xiàn)細(xì)菌、霉菌、酵母、放線菌混雜生長的情況,這使菌落統(tǒng)計(jì)變得非常困難,適合某類菌的分割算法可能不適合其他菌。迅數(shù)的“反式統(tǒng)計(jì)”模塊是專為解決此類復(fù)雜問題而設(shè)計(jì),可實(shí)現(xiàn)多菌混雜平皿中菌落的準(zhǔn)確分割和統(tǒng)計(jì)。
復(fù)雜菌落計(jì)數(shù)-菌落與培養(yǎng)基相似 微生物實(shí)驗(yàn)經(jīng)常會(huì)遇到菌落色澤和培養(yǎng)基很相近的情況,一般算法難以實(shí)現(xiàn)菌落的精確識(shí)別和分割。迅數(shù)菌落儀具備的多處理算法可以為用戶提供更多的解決方案。

復(fù)雜菌落計(jì)數(shù)-暈圈干擾 微生物培養(yǎng)過程中菌落周圍常出現(xiàn)可溶性色素或溶血圈等,迅數(shù)“多相水平集活動(dòng)輪廓模型”可以很好地解決這類問題。

復(fù)雜菌落計(jì)數(shù)-顯色培養(yǎng)基 利用顯色培養(yǎng)基進(jìn)行微生物的篩選分離,其反應(yīng)的靈敏度和特異性大大優(yōu)于傳統(tǒng)培養(yǎng)基。迅數(shù)“RGB約束的水平集活動(dòng)輪廓模型”適合顯色致病菌的識(shí)別和統(tǒng)計(jì)。

雜質(zhì)剔除統(tǒng)計(jì)-形態(tài)學(xué)過濾 微生物菌落計(jì)數(shù)過程中常存在雜質(zhì)問題:如未經(jīng)過濾的樣本直接注入培養(yǎng)皿,培養(yǎng)基中存在不溶物、氣泡、瓊脂凝塊等。利用菌落與雜質(zhì)在形態(tài)學(xué)上的差異,如大小、顏色、輪廓等,設(shè)置一定條件,可濾除特定的雜質(zhì)。

雜質(zhì)剔除統(tǒng)計(jì)-智能識(shí)別算法多樣性 迅數(shù)菌落智能識(shí)別算法的多樣性,為雜質(zhì)、雜菌的剔除提供了豐富的工具。如“動(dòng)態(tài)調(diào)節(jié)統(tǒng)計(jì)”可準(zhǔn)確識(shí)別放線菌,而不受培養(yǎng)基中不溶性成分的干擾。

雜質(zhì)剔除統(tǒng)計(jì)-曝光控制 通常經(jīng)過48小時(shí)培養(yǎng)(或更長時(shí)間),菌落已清晰可見。適當(dāng)控制光照強(qiáng)度、縮短曝光時(shí)間,可使菌落充分展現(xiàn),而細(xì)小雜質(zhì)則因曝光不足被濾除。

雜質(zhì)剔除統(tǒng)計(jì)-背景切換 通過背景切換,可加大菌落與雜質(zhì)的反差,從而實(shí)現(xiàn)菌落的準(zhǔn)確識(shí)別。如褐色中藥粉末,在懸浮式暗視野照明條件下,褐色粉末與黑背景融合,使得灰白菌落突顯,避免了藥渣的干擾。

菌落篩選
雙圈分析 迅數(shù)為抑菌圈、透明圈、變色圈、生長圈等雙圈問題提供了專門的特性分析工具,通過精確測(cè)量外圈直徑和菌落直徑,自動(dòng)計(jì)算二者面積比和直徑比。根據(jù)比值的大小自動(dòng)排序,定位出相應(yīng)的菌落,可用于抗生素、酶制劑、有機(jī)酸等的篩選。

菌種篩選--菌體形態(tài)變異分析 有些菌體的形態(tài)變異與產(chǎn)量的變異存在著一定的相關(guān)性,篩選工作中應(yīng)盡可能捕捉、利用這些直接的形態(tài)特征性變化,將變異菌株篩選出來。迅數(shù)基于水平集活動(dòng)輪廓模型理論,利用菌落在大小、輪廓、色澤等方面的微小特征差異,可準(zhǔn)確識(shí)別目標(biāo)菌落。

霉菌一鍵式測(cè)量 傳統(tǒng)的菌絲生長速率、霉菌生長量、菌絲生長抑制率、室內(nèi)毒力測(cè)定等霉菌研究實(shí)驗(yàn)采用十字交叉法測(cè)量菌落生長直徑。由于多數(shù)霉菌菌落蔓延、疏松、邊緣發(fā)散不規(guī)則,測(cè)量的人為誤差大,效率低。迅數(shù)“霉菌一鍵測(cè)量”模塊,只需用“魔棒”在菌落邊緣點(diǎn)擊一次,即可瞬間測(cè)出大霉菌的面積、周長、長徑、短徑。

抑菌圈測(cè)量
Szone 多模式測(cè)量技術(shù) 管碟擴(kuò)散法要求抑菌圈圓而邊緣清晰,但實(shí)驗(yàn)中仍會(huì)出現(xiàn)抑菌圈邊緣不清晰、破裂等情況,迅數(shù)Szone 抑菌圈多模式測(cè)量技術(shù),運(yùn)用三種不同的高速算法,精確提取構(gòu)成抑菌圈邊緣的像素點(diǎn),從而完成高精測(cè)量。

抗生素效價(jià)測(cè)定 符合中國藥典2020版二劑量法、三劑量法及合并計(jì)算要求。高清晰成像、高精度數(shù)字測(cè)量保證了效價(jià)測(cè)定精度。重復(fù)性自檢的相對(duì)誤差小于0.01%;均勻性自檢的相對(duì)誤差小于0.1%;效價(jià)測(cè)量精度大于99.7%。

舒巴坦敏感β-內(nèi)酰胺酶檢驗(yàn) 抗生素殘留問題成為影響乳制品安全的重要因素之一。為了測(cè)試牛奶中是否添加β-內(nèi)酰胺酶,迅數(shù)提供了一款快速測(cè)量和智能判斷軟件,通過純水驗(yàn)證、平行樣本檢測(cè)、平均值計(jì)算,智能判別β-內(nèi)酰胺酶陽性或陰性。

|